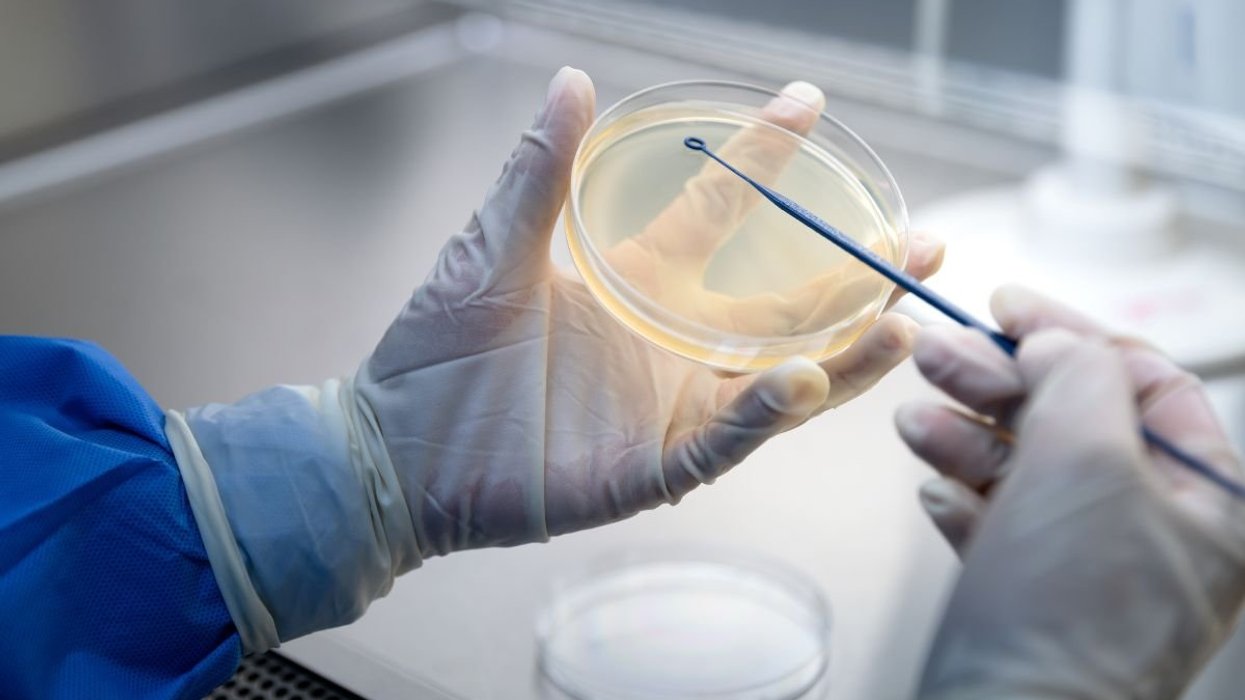
VIRUS DETECTION

Fears millions of LED lights installed across UK are ramping up risk of deadly health issues
'The evidence is already compelling, links to cancer, heart disease, depression, diabetes, an epidemic of insomnia, and yet safer alternatives are available'